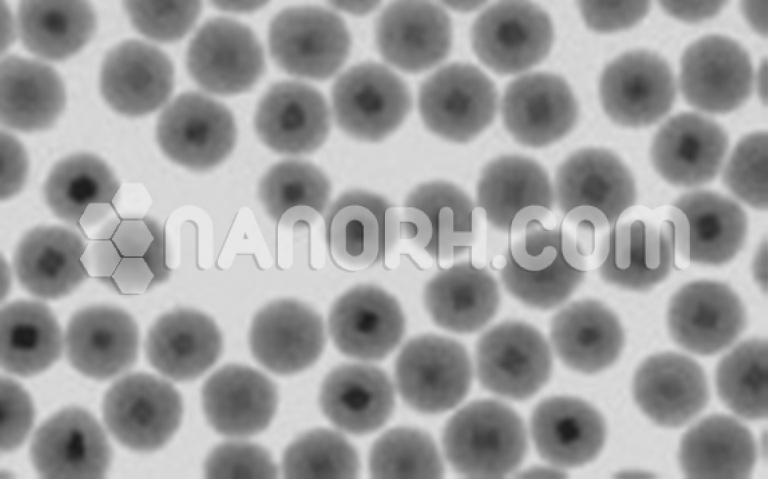
Silicon Oxide (SiO2) Nanoparticles Dispersion Silicon Oxide (SiO2) Nanoparticles Dispersion

Silicon Oxide (SiO2) Nanoparticles Dispersion in 2-Propanol (Amorphous, 25nm, 15wt%)
Nanoparticle dispersions are suspensions of nanoparticles. These dispersions can be used as-is, or diluted with suitable (compatible) solvents. Nanoparticles in dispersions can sometimes settle upon storage, in which case they can be mixed (shaked up) before use……
| Silicon Oxide (SiO2) Nanoparticles Dispersion | |
| Product No | NRE-23048 |
| CAS No. | 60676-86-0 |
| Formula | SiO2 |
| Molecular Weight | 60.08 g/mol |
| APS | <25nm (can be customized) |
| Purity | 99.9% |
| Density | 2.65 g/cm³ |
| Color | White |
| pH | NA |
| Solvent | 85% of 2-Propanol |
Silicon Oxide (SiO2) Nanoparticles Dispersion
Paint, plastic, color rubber, magnetic materials, in addition, nano-silica can be widely used in ceramics (sugar) porcelain, gypsum, batteries, paints, adhesives, cosmetics, glass, steel, fiber, glass, and many other fields of environmental protection products the upgrading.
Note:
</strong.
Nanoparticle dispersions are suspensions of nanoparticles. These dispersions can be used as-is or diluted with suitable (compatible) solvents. Nanoparticles in dispersions can sometimes settle upon storage, in which case they can be mixed (shook up) before use.